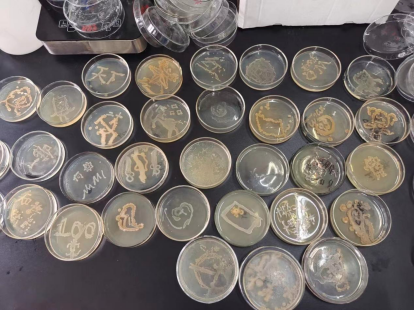

4月16日至17日,西华大学bv伟德国际体育官方网站心理部于5D-302开展了食品与生物工程特色活动——“菌”问归期未有期趣味生物实验。
参加活动的同学们穿好实验服、佩戴好口罩在实验室门口有序地测量体温、洗手消毒进入实验室。同学们三人一组,在研究生师兄师姐的指导下开始活动。师兄师姐耐心的为同学们做实验操作的示范演示,详细的讲解培养基作画的具体步骤以及注意事项。演示结束后,细心叮嘱同学们实验室的注意事项和安全知识。随后开始同学们的实操环节,在师兄师姐指导下在培养基上用接种环画出自己喜欢的图案。作画结束后,大家用马克笔在培养皿上写上自己的记号,放在指定的桌子上。11:00左右所有同学完成作画,随后有序离开实验室。4月17日,同学们去观察了自己作画的培养基,呈现花式各样的团。并结合活动要求评选了此次活动的获奖同学。
此次活动使同学们对微生物实验有了更深入的了解,将所学的微生物知识运用的实验中。同时将心理活动同专业相结合,使得同学们在繁忙的课余时间探索微生物的世界,锻炼了动手能力。
地址:中国·四川·成都·西华大学·第五教学楼D区
版权所有:bevictor伟德-bv伟德国际体育官方网站
电话:028-87720552
传真:028-87720552
官方微信